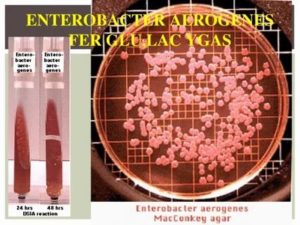
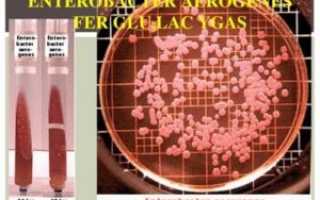

Стрептококк вириданс: характеристика, патогенность, диагностика, лечение
Streptococcus viridans входит в состав естественной микрофлоры человека. Микроб обитает на слизистой оболочке респираторного, пищеварительного и урогенитального трактов. В норме его количество не должно превышать 30% от числа всех микроорганизмов, населяющих данные локусы.
Бактерии распространены повсеместно. В своем обычном состоянии они неопасны для человека. Подавление иммунной защиты — причина активного размножения Streptococcus viridans и приобретения им болезнетворных свойств.
Микроб вызывает местное воспаление и деструкцию клеток слизистой оболочки, выстилающей органы дыхания, пищеварения и мочевыделения. Со временем патогенный стрептококк покидает пределы своей «территории».
Он проникает в кровь и разносится по всему организму, вызывая тяжелые недуги, которые приводят к инвалидности больных и даже летальному исходу.
Streptococcus viridans в переводе с латинского означает зеленый. Такое название связано со способностью бактерий давать при гемолизе зеленую окраску.
Обнаружить микроб в биологическом материале можно с помощью бактериологического исследования или ПЦР. Лечение инфекции этиотропное, патогенетическое, симптоматическое.
Больным назначают пенициллины, иммуномодуляторы и препараты, устраняющие клинические проявления и улучшающие общее состояние пациентов.
Этиология
Streptococcus viridans под микроскопом
Streptococcus viridans — аспорогенные шаровидные или овоидные кокки, лишенные жгутиков. Они образуют капсулу, которая защищает их от фагоцитов, а при определенных условиях трансформируются в L-форму, которая позволяет им скрыться от компонентов иммунной системы.
Бактерии окрашиваются по Граму в синий цвет, в мазке располагаются цепочками. Они очень прихотливы к условиям роста. Для посева используют среды с кровью или сывороткой — кровяной или сывороточный агар. На твердых питательных средах вырастают очень мелкие, сероватые колонии с зоной зеленящего гемолиза по периферии. В жидких средах они образуют диффузную муть с осадком на дне.
Стрептококки способны осуществлять процессы своей жизнедеятельности как в присутствии кислорода, так и без него. Бактерии устойчивы к оптохину и нерастворимы в желчи.
Streptococcus viridans обладает резистентностью к некоторым факторам внешней среды — высушиванию, нагреванию, охлаждению, замораживаю. Погибают микробы при кипячении и дезинфекции, но не сразу, а спустя 15-30 минут.
Находясь долгое время во внешней среде, они теряют свою патогенность.
Стрептококк вириданс считается слабовирулентным микробом. Это связано с ограниченным набором факторов патогенности, к которым относится капсула, белки-адгезины, эндотоксин, гемолизины и ферменты, обеспечивающие развитие патологического процесса.
Эпидемиология
Streptococcus viridans в определенной концентрации не опасен для человека. Скорее наоборот, бактерии предотвращают нашествие других патогенов и защищают организм человека от таких опасных микробов, как Pseudomonas.
Когда количество стрептококка начинает стремительно расти, возникает патология. Пополнение стрептококка также возможно извне – от больных людей, особенно с респираторными формами недуга, а также от бессимптомных бактерионосителей. Пациенты с поражением органов дыхания постоянно выделяют микробы в окружающую среду.
Источниками инфекции могут стать собственные очаги — воспаленные пазухи носа или кариозные зубы. Слизь из носа, стекая по задней стенке глотки, вызывает периодически воспаление горла и миндалин.
Пути распространения инфекции:
- Аэрационный – при заглатывании воздуха, содержащего микробы,
- Контактный, в том числе половой — при поцелуе, объятии, коитусе,
- Алиментарный — при употреблении инфицированных продуктов питания: яиц, молока, ветчины,
- Трансплацентарный — внутриутробное заражение плода.
Восприимчивость людей к стрептококковой инфекции довольно высокая. Для недуга характерна осенне-зимняя сезонность. Микроб поражает преимущественно маленьких детей и пожилых людей.
Факторы, способствующие развитию патологии:
- Иммунодефицит,
- Перенесенная ОРВИ,
- Переохлаждение,
- Контактирование с больным человеком,
- Онкопатологии,
- Длительная иммуносупрессия,
- Сопутствующие хронические заболевания в стадии декомпенсации.
После внедрения Streptococcus viridans в организм человека происходит развитие местных воспалительных процессов и формирование первичного очага поражения.
Данный микроб обладает тропностью к эпителию респираторного тракта, поэтому чаще всего местом его локализации становятся верхние дыхательные пути. В более редких случаях воспаляются органы мочевыделительной и пищеварительной систем.
Бактерии активно размножаются в эпителиоцитах. Когда их количество становится запредельным, стрептококки прорываются в кровеносное русло и разносятся к внутренним органам.
Streptococcus viridans способен вызвать тяжелую интоксикацию с диспепсией и спутанностью сознания. Клеточная стенка бактерий воспринимается организмом как аллерген, к которому вырабатываются аутоантитела и гиперчувствительность.
Происходит аллергизация организма, развиваются аутоиммунные процессы, протекающие в форме гломерулонефрита, миокардита, ревматизма.
Не смотря на свою низкую вирулентность, стрептококк вириданс способен проникать с током крови даже в стерильные среды – ликвор, мочу.
Заболевания, которые вызывает Streptococcus viridans:
- Деминерализация и разрушение твердых тканей зуба с образованием полостного дефекта,
- Воспаление тканей пародонта,
- Тонзиллит, фарингит,
- Отит,
- Воспаление почечных клубочков,
- Уретрит,
- Цервицит,
- Воспаление лимфоузлов, мышц, кожи,
- Эндокардит.
Симптомы
Streptococcus viridans обычно вызывает заболевания верхних отделов дыхательного тракта. У ребенка этот микроб обнаруживается в горле и становится возбудителем фарингита или ангины.
На фоне выраженного интоксикационного синдрома с лихорадкой, недомоганием и апатией появляется боль в горле, тошнота, охриплость. Больные дети часто капризничают, плачут, отказываются от еды, не берут грудь.
У них появляются желто-зеленые выделения из носа, кашель, головная боль.

При осмотре специалисты обнаруживают гиперемированную слизистую оболочку зева, отек и гипертрофию миндалин. У больных лицо становится одутловатым, возникает регионарный лимфаденит, появляется гнойничковая сыпь на коже, миалгия, артралгия, гипергидроз.
Осложнения заболеваний, вызванных Streptococcus viridans:
- Острый средний отит,
- Ревматизм,
- Воспаление миокарда,
- Гломерулонефрит,
- Бактериальное воспаление мозговых оболочек,
- Абсцессы паренхиматозных органов,
- Сепсис,
- Шок.
Патогенез подобных осложнений до конца не известен. Их причиной считается аутоиммунное воспаление: антитела, вырабатываемые для борьбы с инфекцией, реагируют на собственные клетки, пораженные стрептококком.
Лабораторные методы исследования
Диагностика заболеваний, вызванных Streptococcus viridans, заключается в проведении микробиологического исследования клинического материала и постановке полимеразной цепной реакции. Начинается лабораторная диагностика с отбора материала. Микробиологи исследуют мазок из зева и миндалин, отделяемое носа, влагалищный секрет, соскоб с пораженного участка кожи, кровь, мочу, мокроту, ликвор.
Бактериологическое исследование — «классика» диагностики инфекционных заболеваний. Отобранный материал в стерильных пробирках или контейнерах доставляют в микробиологическую лабораторию для выделения возбудителя.
Его засевают на кровяной агар и одну из сред накопления — сахарный или сывороточный бульон. После суточной инкубации учитывают результаты. При микроскопии выросших колоний обнаруживают синие кокки, расположенные цепочками. Особый интерес представляют колонии с зоной зеленящего гемолиза.
Именно они содержат патогенные микроорганизмы. Колонии с гемолизом подсчитывают и определяют степень микробной обсемененности. После выявления биохимических и антигенных свойств делают заключении о принадлежности данного микроба к виду Streptococcus viridans и сравнивают его количество с предельно допустимым.
В норме стрептококк вириданс не должен превышать 10 в 4 степени микробных клеток. Когда количество микроорганизма в зеве составляет 10 в 5 степени и более, говорят об его этиологической роли в развитии данного недуга.
Для клиницистов важен не только вид и количество возбудителя, но и его чувствительность к антибактериальным препаратам. Чтобы ее определить, ставят специальный тест с набором антибиотиков из разных групп.
ПЦР-диагностика – современный метод, позволяющий обнаружить инфекцию путем выделения генетического материала возбудителя. Этот экспресс-тест дает точный результат за считанные минуты.
Но по современным стандартам больным необходимо пройти всестороннее обследование, которое длится несколько дольше, но дает более достоверный результат.
Поскольку стрептококк вириданс является нормальным обитателем организма человека, с помощью ПЦР он может обнаруживаться и у здоровых людей. Именно поэтому данный метод не является универсальным.
К дополнительным исследованиям относятся параклинические анализы крови и мочи, ЭКГ, УЗИ внутренних органов. Эти исследования необходимы для определения состояния сердца и почек. Очень часто стрептококк распространяется гематогенным путем из очагов, расположенных в клубочковых образованиях или клапанном аппарате.
Общетерапевтические мероприятия
Стрептококковая инфекция опасна своими осложнениями, поэтому ее лечение следует начинать незамедлительно. Лечение инфекции, вызванной Streptococcus viridans, заключается в воздействии на первопричину — микроб и в устранении клинических проявлений, ухудшающих самочувствие больных.
Для этого применяют традиционные лекарственные и физиотерапевтические методики, а также средства народной медицины. Комплексный подход дает максимально положительный результат. В среднем курсовой прием препаратов длится 7-10 дней.
Проводится лечение под контролем специалистов — ЛОР-врачей, инфекционистов или пульмонологов.
- Лечение стрептококковой инфекции требует применения антибиотиков. Больным назначают пенициллины «Аугментин», «Амоксициллин» и цефалоспорины «Цефтриаксон», «Цефтазидим». Антибиотикотерапию проводят до полной санации, после чего сдают повторно анализ на микрофлору.
- Полоскания горла стрептококковым бактериофагом, «Мирамистином», «Хлоргексидином».
- Энтеросорбенты для дезинтоксикации – «Полисорб», «Смекта».
- Для восстановления нарушенной микрофлоры кишечника принимают пре- и пробиотики – «Линекс», «Аципол», «Бифидумбактерин».
- Иммуностимулирующие препараты – «Ликопид», «Бронхомунал», «Полиоксидоний».
- Десенсибилизирующие средства для снятия отечности — «Тавегил», «Зиртек», «Лоратодин».
- Жаропонижающие и противовоспалительные средства – «Парацетамол», «Нурофен».
- Сосудосуживающие капли в нос – «Тизин», «Ксилометазолин».
- Дезинтоксикация и дегидратация заключается в употреблении достаточного количества жидкости, пероральном приеме «Регидрона», парентеральном введении физраствора и глюкозы.
- Полоскания ротовой полости и горла настоями и отварами лекарственных трав.
- Употребление внутрь природных антисептиков — меда, прополиса, чеснока, лука.
- Обогащение рациона витаминами – овощами и фруктами.
- Отвар шиповника и клюквенный морс насыщают организм витамином С и повышают иммунитет.
- Отвар из листьев и ягод черники – хороший антисептик и иммуностимулятор.
- Лечение эндокардита проводят путем оперативного вмешательства – микробные вегетации на клапанах удаляют, утолщенный эндокард иссекают, а затем выполняют пластику.
Особое внимание следует уделять уходу за больными, их питанию и соблюдению питьевого режима.
Профилактические процедуры
Специфическая профилактика стрептококковой инфекции в настоящее время не разработана. Чтобы предупредить развитие патологии, специалисты дают следующие рекомендации:
- Соблюдать правила личной гигиены: проводить регулярно влажную уборку помещения, мыть руки перед едой, содержать в чистоте предметы обихода, посуду, детские игрушки.
- Закаляться, вести активный образ жизни, заниматься посильными видами спорта.
- Полноценно и правильно питаться, включать в рацион обогащенный витаминами и микроэлементами продукты питания, готовить каждый день свежие блюда, следит за сроком годности сырья и продуктов.
- Бороться с вредными привычками, отказаться от чрезмерного и частого употребления спиртных напитков, не курить, не допускать пассивного курения.
- Своевременно выявлять и изолировать больных в стационар для адекватного и комплексного лечения под наблюдением специалистов.
Стрептококк вириданс может спокойно сосуществовать с людьми. Развитие патологии происходит при снижении иммунитета или проникновении микробов с патогенными свойствами извне.
При отсутствии леченых мероприятий стрептококк из своих традиционных очагов — зева и горла опускается в нижние отделы респираторного тракта — бронхи и легкие, а также проникает с током крови в другие органы.
Своевременная и адекватная терапия делает прогноз патологии благоприятным, не позволяя развиться опасным для жизни осложнениям.
: стрептококк – доктор Комаровский
Мнения, советы и обсуждение:
Источник:
Streptococcus viridans, стрептококк вириданс: норма и патология, свойства, лечение — ЛОР ОНЛАЙН
В микрофлоре человека бурлит своя лишь ей присущая жизнь. Научным работникам понадобились длительные годы, чтобы определить, насколько много самых различных бактерий живет во рту у человека, его глотке, желудочно-кишечном тракте, половых и всех остальных органах. Многие из них приносят невероятную помощь в работе той или иной системы, оставаясь при этом практически не замеченными.
Есть среди них и те, которые до определенного момента живут и не причиняют вреда человеку. Но может случиться сбой в организме и та бактерия, которая еще вчера была безвредной становится очень опасной. Именно такими бактериями и являются стрептококки, в частности стрептококк вириданс.
Они не всегда опасны для людей. Но так длится лишь до тех пор, пока они находятся в нормальных условиях. Стоит только случиться внутри организма какому-нибудь колебанию на фоне болезни или пониженного иммунитета, стрептококки сразу же дают о себе знать.
Что такое стрептококки?
Данные микроорганизмы —, это отдельный род бактерий, живущих внутри людей и животных. Группа стрептококков представляет собой довольно обширную зону. Эти условно-патогенные микроорганизмы нередко находят пристанище в человеческом теле. Большая часть их видов так и остается незамеченной на протяжении всей жизни человека.
Чего нельзя сказать о стрептококке вириданс или зеленящем, который является неотъемлемой частью нормальной микрофлоры в полости рта, глотке, ЖКТ, в органах дыхания. Таких микроорганизмов огромное количество в природе. Они до определенного момента не причиняют людям вреда.
Но стоит произойти сбою в иммунной системе человека, как присутствие бактерий становится невероятно опасным.
Streptococcus viridans
Простейшие микроорганизмы, локализующиеся в полости рта, ЖКТ, в системе органов дыхания и мочеполовой системе и составляют около 30–60% из всех бактерий, находящихся в людях. Проникают они в организм вместе с пищевыми продуктами.
С помощью светового микроскопа можно рассмотреть, как они выглядят. Данные бактерии представляют собой неподвижную цепочку, состоящую из шариков. Соприкосновение их с клетками крови изменяет цвет бактерий, поэтому их еще называют зелеными.
- Самыми частыми отрицательными последствиями деятельности этих бактерий являются следующие заболевания:
- При проникновении стрептококков в кровеносные сосуды, сердце, мозг и мочеполовую систему могут возникнуть необратимые осложнения.
- Существует много путей попадания стрептококков в кровеносную систему:
Диагностика
Диагностировать стрептококк вириданс возможно только в лабораторных условиях. В наше время делается это с помощью экспресс-тестов на протяжении нескольких минут. Помимо этого, есть определенные нормы, обязывающие проходить стандартные обследования. На них уходит немного больше времени, но верность результата впечатляет.
Во время стандартной диагностики проводятся все виды обследования, которые способствуют выявлению других болезнетворных микроорганизмов:
Важно знать, что данная бактерия может находиться в любом месте, поэтому, чтобы определить ее местонахождение иногда нужно прибегнуть к сдаче нескольких анализов.
Лечение
Избавиться от данной проблемы можно с помощью антибиотиков пенициллинового ряда и иммуномодуляторов.
Во время лечения детей и женщин используются лекарства более мягкого воздействия. К лечению каждого пациента необходим индивидуальный подход.
В случае аллергических проявлений на медикаменты пенициллинового ряда они заменяются сульфаниламидами.
Токсические вещества выводятся при помощи Атоксила. Есть возможность предупредить рецидив с помощью иммунотерапии.
Народные методы борьбы с стрептококком
Лечиться при помощи народных методов можно, но при этом не стоит исключать медикаментозную терапию. Только так можно достичь положительных результатов.
Существуют определенные продукты питания, которые оказывают антисептические действия. В первую очередь – это продукты пчеловодства – мед, прополис, пчелиная пыльца. Наравне с ними с микробами борются лук и чеснок.
Заболевания горла на фоне стрептококковой инфекции, кроме антибактериальной терапии, желательно сопровождать полосканием горла отваром ромашки, череды или календулы.
Для полного выздоровления организму необходимо достаточное количество витаминов и полезных микроэлементов. Все эти ценные вещества находятся в овощах и фруктах.
Осложнения
Отсутствие необходимого лечения стрептококков приводит к развитию в организме гнойных процессов, что чревато возникновению буквально в считанные дни таких осложнений, как:
В целях профилактики данного заболевания достаточно соблюдать правила личной гигиены и укреплять иммунную систему. При своевременном лечении многих возможных негативных осложнений удается избежать.
Источник:
Стрептококк вириданс: лечение у человека
Рассказать ВКонтакте в Одноклассниках в
Бактерии, невидимые невооруженным глазом, могут вызвать серьезные воспалительные процессы. Почему происходит бурное развитие микроорганизмов вириданс, как этот стрептококк влияет на здоровье человека? Полезно узнать симптомы инфекционного поражения, методы диагностики и лечения болезней.
Что такое стрептококк вириданс
Простейшие микроорганизмы являются важной частью микрофлоры организма, участвуют в работе его систем. Стрептококк вириданс (Viridans streptococcus) не представляет опасности, считается условно-патогенным, пока человек здоров. Бактерии чаще находятся в полости рта, но могут локализоваться в органах:
- мочеполовой системы;
- желудочно-кишечного тракта;
- системы дыхания.
При снижении защитных сил организма происходит активное размножение стрептококков. Бактерии вириданс имеют такие особенности:
- попадают к человеку с пищей, во время лечения зубов, при хирургическом вмешательстве;
- при снижении иммунитета вызывают инфекции, отличающиеся тяжелым течением;
- попадая в кровеносную систему, распространяются по всему телу, поражают удаленные органы, вызывают гемолиз (разрушение клеток крови).
Стрептококки устойчивы к воздействию внешней среды. Бактерии вириданс характеризуют такие свойства:
- Микроорганизмы, находящиеся в крови, мокроте, могут сохранять жизнеспособность в течение нескольких месяцев.
- При воздействии температуры плюс 60 градусов бактерии гибнут через полчаса.
- Обработка дезинфицирующими растворами уничтожает вириданс через 15 минут.
Какие заболевания провоцирует
Когда по различным причинам происходит резкое снижение иммунитета, стрептококк начинает бурно размножаться и распространяться по организму. Небольшая бактерия вириданс поражает клетки органов, вызывая серьезные заболевания. У пациента могут развиться:
- миозит (воспалительный процесс скелетной мускулатуры);
- рожистая инфекция;
- поражения суставов, мышц;
- уретрит (воспаление мочеиспускательного канала);
- абсцесс мягких тканей;
- фасцит (пяточная шпора);
- пиелонефрит, нефрит (воспалительные процессы в почках);
- кариозное поражение зубов.
Стрептококк вириданс в горле может спровоцировать фарингит (воспаление слизистой оболочки глотки), ангину (острое гнойное поражение миндалин). При размножении микроорганизмов не исключено появление таких заболеваний:
- пародонтоза;
- бронхита;
- лимфаденита (гнойного воспаления лимфоузлов);
- скарлатины;
- отека ушных раковин;
- пневмонии;
- стрептодермии (гнойного поражения кожных покровов);
- отита;
- менингита (воспаления мозговых оболочек);
- ревматизма;
- цервицита (воспаления шейки матки);
- инвазивных инфекций после ожогов;
- послеродового сепсиса.
Микроорганизмы могут вызвать острую форму инфекционного эндокардита. Стрептококк и стафилококк вириданс, оседая на створках сердечных клапанов, приводят к их деформации. У пациентов в этой ситуации может развиться:
- микробная эмболия сосудов (ограничение поступления крови из-за уменьшения их просвета), как следствие, – инфаркт, инсульт;
- абсцесс (гнойное воспаление) головного мозга;
- аневризма (выпячивание) артерий;
- сердечная недостаточность;
- энцефалопатия (поражение головного мозга).
Воспалительные процессы развиваются стремительно, поэтому важно при появлении признаков заболевания обратиться за помощью к врачам. Своевременное лечение поможет избежать опасных последствий. При распространении стрептококка вириданс наблюдается повышение температуры до субфебрильных значений (около 37,5 градуса). О начале развития патологических процессов могут говорить такие симптомы:
- аллергические высыпания на коже;
- снижение работоспособности;
- общее недомогание;
- отсутствие аппетита;
- лихорадка;
- озноб;
- слабость;
- тошнота;
- апатия.
Заражение организма стрептококком вириданс нередко сопровождается появлением признаков недуга, которые зависят от локализации инфекции:
| Заболевание | Что поражается | Симптомы |
| Фарингит | Слизистая задней стенки глотки |
|
| Стрептодермия | Кожные покровы | гнойничковая сыпь |
| Ангина | Миндалины |
|
| Пародонтит | Десны | отечность кровоточивость |
Бактерии str. viridans вызывают серьезные инфекции, при которых может наблюдаться такая клиническая картина:
| Заболевание | Что поражается | Симптомы |
| Рожистое воспаление | Кожные покровы, слизистые | высокая температура, покраснение кожи пузыри с жидкостью |
| Бронхит | Бронхи |
|
| Пневмония | Легкие | |
| Лимфаденит | Лимфатические узлы | болезненность увеличение размеров |
| Уретрит | Мочеиспускательный канал | боли при мочеиспускании повышение температуры |
| Цервицит | Шейка матки | вагинальные выделения |
Когда стрептококки попадают в кровоток и распространяются по организму, не исключено развитие опасных патологий, которые сопровождаются такими симптомами:
| Заболевание | Что поражается | Симптомы |
| Отит | Ухо | гнойные выделения стреляющая боль |
| Менингит | Мозговые оболочки |
|
| Эндокардит | Клапаны сердца |
|
| Кариес | Зубы | нарушение эмали боль |
Фарингит симптомы
Энтеробактер: что это такое, чем опасно для человека
Энтеробактеры представляют собой грамотрицательные бактерии, имеющие форму палочек, покрытых жгутиками. Они не образуют спор, развиваются в анаэробных условиях, но способны выживать в присутствии кислорода. Большинство данных микроорганизмов входят в состав нормальной кишечной микрофлоры человека и животных, а некоторые обитают в воде, почве и продуктах питания.
Энтеробактер под микроскопом выглядит как палочка со жгутиками
Типичные представители энтеробактерий
Бактерии рода Enterobacter относятся к семейству enterobacteriaceae и включают в себя 12 видов, относящихся преимущественно к условно патогенной флоре, населяющей кишечник человека. Наибольший интерес для медиков имеют энтеробактеры, которые при определенных условиях способны вызывать заболевания у людей.
- Enterobacter cloacae является представителем нормальной микрофлоры дистального отдела кишечника. Но после приема антибиотиков, при снижении иммунитета или развитии дисбактериоза, его усиленное размножение приводит к нарушению работы ЖКТ. Из-за непосредственной близости ануса к наружным половым органам у женщин может происходить инфицирование, приводящее к вагинитам, цервицитам и воспалениям других отделов мочеполовой системы. Развитие микроорганизмов в дыхательных путях приводит к тяжелой форме пневмонии, а вот проникновение их в кровяное русло вызывает септицемию.
- Enterobacter aerogenes чаще других микробов является причиной больничных инфекций. Особую опасность представляет инфицирование внутрисосудистых катетеров, шунтов и протезов, провоцирующее инфекционный эндокардит, тромбофлебит или общий сепсис.
- Enterobacter agglomerans, обозначенные в современной литературе термином Pantoea agglomerans, поражают преимущественно органы мочеполовой системы мужчин и женщин, а также респираторный тракт.
- Enterobacter sakazakii, отнесенный в последнее время к роду Cronobacter, представляет большую опасность для новорожденных детей, особенно, имеющих недостаточную массу тела, аномалии развития и врожденные заболевания иммунной системы. Доказано, что Энтеробактер саказаки вызывает инфекционное воспаление оболочек головного и спинного мозга, образование некротических очагов на стенках кишечника, явления сепсиса.
- Enterobacter gergoviae, переименованный в Pluralibacter gergoviae, вызывает кишечные расстройства, поражения органов выделения, дыхания и размножения.
Другие условно патогенные бактерии рода энтеробактер, к которым относятся Enterobacter asburiae, Enterobacter hormaechei, Enterobacter ludwigii и Enterobacter kobei поражают преимущественно ЖКТ и респираторные органы.

Обнаружить микроб можно в разных средах человеческого организма
Иногда в результатах анализов встречается термин «лактозонегативные энтеробактерии», что указывает на наличие микроорганизмов, препятствующих правильному перевариванию продуктов и вызывающих изжогу, метеоризм, диарею, срыгивание и другие диспептические явления. В составе нормальной микрофлоры их количество не должно превышать 5%.
Таксономическая принадлежность
Род: Enterobacter
Семейство: Enterobacteriaceae
Группа: V грамотрицательные факультативные анаэробы
Отдел: I грамотрицательные микроорганизмы
Царство: Prokaryote
Название рода было утверждено в 1963 году. Но проведенные в последующем исследования генома привели к существенным изменениям в систематике. В результате этого E.agglomerans выделили в отдельный род Pantoea, а E.sakazakii отнесли к роду Cronobacter.
Поэтому современная классификация включает 12 видов бактерий рода энтеробактер, из которых наибольшее эпидемиологическое значение имеют энтеробактер клоака и аэрогенес.
Строение, жизненный цикл и свойства микробов
По внешнему строению энтеробактеры напоминают прямые палочки. Их тело полностью покрыто жгутиками, обеспечивающими движение. Единственным неподвижным видом является E.asburiae.
Выращивание в лабораторных условиях позволяет выявить Enterobacter в анализах
Диаметр микроорганизмов колеблется от 0,6 до 1 мкм, а длина — от 1.2 до 3 мкм.
При диагностическом исследовании в мазках обнаруживаются единичные или соединенные в короткие цепочки бактерии.
Все представители кишечной группы рода энтеробактер быстро растут на стандартных и селективно-дифференциальных питательных средах.
Бактерии принадлежат к группе факультативных анаэробов, не образуют спор, но у некоторых штаммов имеются капсулы. Местом их обитания являются слизистые оболочки кишечного тракта, органов мочеполовой системы и дыхания. При этом микроорганизмы способны выживать в экскрементах, почве, водоемах, на растениях, кожных покровах животных и других объектах внешней среды.
Род энтеробактер становится заразен для людей в период снижения резистентности организма или после длительного курса антибиотикотерапии. В первую очередь ускоряется пролиферация Enterobacter cloacae в тонком кишечнике, что для данных бактерий не характерно, так как большинство их населяет толстый отдел.
Энтеробактеры опасны для новорожденных младенцев с ослабленным иммунитетом в период прохождения через родовые пути. Инфицирование человека может произойти при попадании большого количества микроорганизмов с недоброкачественными продуктами питания или при заглатывании воды в открытых водоемах.
Низкая чувствительность к антибиотикам у представителей энтеробактер приводит к тому, что они быстро замещают лакто- и бифидобактерии, количество которых резко снижается во время продолжительного применения человеком антибиотиков. Такой дисбактериоз приводит к возникновению заболеваний.
Лабораторная диагностика: что означают цифры
У взрослого человека в кишечнике содержание микроорганизмов рода энтеробактер, включающих в себя Enterobacter cloacae, aerogenes и другие виды, не должно превышать 104 колониеобразующих единиц на 1 г кала.
Бактерии энтеробактер в кале ребенка появляется с первых дней жизни, но его количество и соотношение с другими микроорганизмами будет постоянно изменяться, так как в первые 3-4 месяца идет интенсивное заселение кишечника. Искусственное введение в организм малыша бифидо и лактобактерий позволяет поддерживать баланс микрофлоры кишечника.
При выявлении у новорожденных детей пневмонии, возникает подозрение на инфицирование их во время прохождения родовых путей.
В этом случае у матери в мазке из цервикального канала обнаруживается Enterobacter aerogenes с концентрацией более 105КОЕ.
Чтобы предотвратить такой путь заражения беременным проводят бакпосев на обнаружение Enterobacter aerogenes, Cronobacter sakazakii и некоторых других микроорганизмов, выявляемых при обычном бакпосеве.

Инфицирование ребенка может произойти, если в грудном молоке матери высеян энтеробактер, концентрация которого превышает допустимые показатели. Однако диагноз подтверждается после возникновения характерных клинических признаков и обнаружении Enterobacter cloacae в кале у ребенка в количестве, превышающем 104КОЕ.
Анализ мочи проводится для выяснения причин возникновения урогенитальных инфекций и выявления скрытых воспалений почек и мочевого пузыря.
Если при отсутствии клинических симптомов у женщин концентрация энтеробактер в 1 мл мочи превышает 105КОЕ, то диагноз подтверждается, и назначается курс лечения.
Если же количество в моче Enterobacter cloacae ниже данного показателя, то это свидетельствует о загрязнении лабораторного материала во время его забора.
Если клиника заболевания имеет выраженный характер, то допустимый порог в 1 мл мочи составляет не более Enterobacter cloacae 10 в 4 степени.
Делая посев из зева, следует знать, какая норма энтеробактер аэрогенес должна быть у человека, так как ее превышение может спровоцировать тяжелую форму пневмонии. Если показатель превышает Enterobacter aerogenes 10 2КОЕ и сопровождается клиническими признаками, то следует начинать немедленное лечение.
Пациенты, у которых выявлено наличие энтеробактера клоаке в горле, но не имеющие симптомов поражения респираторного тракта, считаются носителями. У них значительно повышается риск возникновения пневмонии при попадании в условия стационара, так как на ее долю приходится 10% случаев от совокупности внутрибольничных инфекций.
Для определения рисков инфекции разработаны стандарты лабораторной диагностики
Норма энтеробактер клоаке в зеве составляет от 102 до 104КОЕ, но при этом их количество не должно значительно превышать концентрацию других форм нормальной микрофлоры.
В чем опасность для человека
Наибольшую опасность энтеробактеры представляют для новорожденных, так как вызывают:
- менингит;
- гнойное воспаление почек и мочевыводящих путей;
- некротический колит;
- тяжелые поражения кровеносной и лимфатической системы;
- гнойничковые и язвенные поражения кожи у грудничков.
Летальность при этом составляет от 55 до 80%.
Респираторные заболевания, вызванные Enterobacter cloacae, которые локализуются в горле, проявляются повышением температуры тела, слабостью и продуктивным кашлем.
Опасность данных инфекционных заболеваний заключается в том, что даже при грамотной своевременной терапии могут наблюдаться параличи, резкое падение кровяного давления, приводящее к потере сознания, асфиксия. Смертность составляет до 25%.
Энтеробактеры являются возбудителями бактеремий, при которых происходит интенсивное размножение микроорганизмов в крови, приводя к развитию патологий во всех внутренних органах.
У мужчин бактерии рода энтеробактер часто вызывают простатиты и уретриты. У женщин они становятся причиной воспалений органов мочеполовой системы, которые очень тяжело поддаются лечению.
Наиболее восприимчивыми являются люди, перенесшие серьезные травмы, больные сахарным диабетом, а также другими болезнями, подавляющими синтез клеток иммунитета.
Особенности лечения
Так как представители рода Enterobacter spp.
устойчивы ко многим антимикробным препаратам, то перед началом лечения необходимо установить чувствительность выделенного микроорганизма к конкретному антибиотику.
Далее назначается комплексная терапия, позволяющая, как избавиться от представителей энтеробактер и устранить симптомы вызванного ими заболевания, так и повысить общую резистентность организма.
С этой целью применяются аминогликозиды, Бета-лактамы, тетрациклины и цефалоспорины 3-го поколения. Наиболее широкое применение в борьбе с энтеробактер клоаке и аэрогенес нашел Метронидазол, Пиперациллин, Цефтриаксон, Ко-амоксиклав, Гентамицин.
Целесообразны комбинации антимикробных препаратов и средств, потенцирующих их действие. Но такое совмещение может назначаться только врачом после получения результатов лабораторных анализов.
Инновацией в лечении заболеваний, вызванных энтеробактерами, является применение бактериофага Энтеробактер поливалентного очищенного. Ранее ученым не удавалось создать бактериофаг, какой бы объединял несколько фагов рода энтеробактер, включающих в себя Э.
клоака, Э. аэрогенес и Э. аггломеранс, отделенных от метаболитов бактерий.
Его эффективность доказана при следующих патологиях:
- ЛОР-заболевания;
- гастроэнтероколиты;
- хирургические гнойные инфекции;
- пневмонии;
- дисбактериоз;
- заболевания мочеполовой сферы у мужчин и женщин.
Данный препарат может применяться детям с первых дней жизни.
Другим проверенным средством против бактерий энтеробактер является бактериальный Секстафаг, воздействующий также на стафилококки, стрептококки, протеи, клебсиеллы и кишечную палочку.
Прежде, чем лечить заболевания, вызванные Enterobacter aerogenes у беременной женщины, следует знать о возможных патологиях, развивающихся у плода при приеме следующих лекарственных средств:
- нитрофураны: гемолитическая анемия;
- сульфаниламиды: желтуха и гемолитическая анемия;
- аминогликозиды: отрицательное влияние на слух и работу почек;
- нитроксолин: атрофия зрительного нерва.
Поэтому, выбирая, чем лечить инфекции, спровоцированные энтеробактер аэрогенес пациенткам в период вынашивания плода, медики отдают предпочтение пенициллинам и цефалоспоринам в сочетании с пробиотиками и щадящим рационом питания.
Лечение болезней, вызванных возбудителями энтеробактер, средствами народной медицины сводится к усилению иммунитета, восстановлению баланса микрофлоры кишечника, а также дезинфекции ротовой полости и влагалища у женщин. С этой целью применяются травяные сборы, в состав которых входит ромашка, зверобой, кора дуба, полынь, шалфей и некоторые другие травы.
Перед использованием любых народных методов необходимо проконсультироваться с врачом, так как самолечение может скрыть клинические симптомы заболевания, и инфекция перейдет в хроническую форму или вызовет осложнения.
Работаю врачом ветеринарной медицины. Увлекаюсь бальными танцами, спортом и йогой. В приоритет ставлю личностное развитие и освоение духовных практик. Любимые темы: ветеринария, биология, строительство, ремонт, путешествия. Табу: юриспруденция, политика, IT-технологии и компьютерные игры.
Источник:
Как лечить энтеробактер в горле
Энтеробактерии — большая группа микроорганизмов, обитающих в различных отделах ЖКТ и оказывающих позитивное или патогенное воздействие на организм человека. Все энтеробактерии подразделяются на три группы: патогенные, условно-патогенные и сапрофитные.
- Большинство энтеробактерий являются представителями микробного биоценоза кишечника. Это клебсиелла, энтеробактер, серрация, протей, цитробактер, провиденция и иерсиния. Они выполняют в макроорганизме жизненно важные функции, но под воздействием негативных факторов становятся опасными и вызывают различные заболевания.
- К абсолютным патогенам относятся шигеллы, сальмонеллы и некоторые виды эшерихий. Эти микробы, попав в организм человека извне, вызывают острые кишечные инфекции и прочие патологии, угрожающие жизни больного.
- Сапрофитные энтеробактерии не опасны в эпидемиологическом отношении и не имеют значения для практической медицины.
возбудители кишечных инфекций
В семейство Enterobacteriaceae входит множество родов и видов, способных вызвать развитие серьезных заболеваний у человека. Одним из основных представителей данного семейства является энтеробактер.
Он считается нормальным обитателем кишечника человека, обеспечивающим его адекватное функционирование. Проникая в другие органы, этот микроб становится причиной серьезных недугов. Чаще всего поражаются почки, мочевыводящие пути, органы репродуктивной и дыхательной систем.
Enterobacter spp – одна из ведущих причин смерти новорожденных детей.
Патогенез
Заболевания, обусловленные энтеробактериями, чаще всего развиваются у лиц с иммунодефицитом.

Группу риска по энтеробактериальной инфекции составляют:
- Новорожденные,
- Пожилые люди,
- Часто болеющие лица,
- Больные хроническими патологиями ЖКТ,
- Пациенты, длительно находящиеся на стационарном лечении.
Кишечные микробы вызывают не только заболевания органов пищеварения, но и близлежащих структур. Воспаление может развиться практически в любой части тела человека: от зева до ануса.
Патологии, которые вызывают энтеробактерии:
- Дисбактериоз, дизентерия, сальмонеллез, эшерихиоз.
- Воспаление мочевыводящих путей и органов.
- Пневмония.
- Менингит, абсцедирование мозговой ткани и прочие ликворные нарушения.
- Инфекция органов женской репродуктивной системы.
- Воспаление органов гепатобилиарной зоны.
- Гематогенные расстройства — бактериемия, сепсис.
Энтеробактерии являются возбудителями внутрибольничных инфекций. Микробы проникают в кровяное русло при проведении инвазивных манипуляций, катетеризации мочевого пузыря или внутривенного введения нестерильных лекарств. В обширных очагах довольно сложно снизить активность бактерий.
В результате взаимодействия возбудителя и соответствующих структур макроорганизма развивается инфекционный процесс, который состоит из адгезии, инвазии, колонизации, токсинообразования.
Энтеробактер обладает тропизмом к эпителиоцитам кишечника. Адгезия осуществляется за счет приближения микроба, а также взаимодействия его ворсинок с рецепторами эпителия. Бактерии проникают внутрь клетки и начинают активно размножаться. Процессы колонизации и токсинообразования определяют выраженность и разнообразие клинических проявлений инфекции.
Симптоматика
Энтеробактериозы обычно протекают без каких-либо особенностей в симптоматике. Клинические признаки заболеваний определяются локализацией очага поражения и видом возбудителя.
Общие проявления патологии:
- Боль в очаге поражения различной интенсивности, длительности, распространенности.
- Общее недомогание, слабость, вялость, разбитость, снижение работоспособности.
- Признаки воспаления на гемограмме – лейкоцитоз и подъем СОЭ.
- Лихорадка, озноб, миалгия, артралгия, бледность кожи, снижение аппетита, нарушение сознания.
- Диспепсия — тошнота, рвота, изжога, метеоризм.
- Нарушение стула — изменение консистенции, появление патологических примесей.
Enterobacter aerogenes является возбудителем менингита, который нередко осложняется абсцедированием вещества мозга. У больных возникает интоксикация, очаговые неврологические симптомы, менингеальные знаки. При поражении мочевыводящих путей у больных появляется дизурия, боль в конце акта мочеиспускания.
Воспаление желчного пузыря и протоков проявляется болью и спазмами в правом подреберье. Воспалительный процесс в легочной ткани развивается у каждого четвертого носителя. У больных на фоне выраженной интоксикации возникает кашель с гнойной мокротой.
При отсутствии соответствующей терапии формируются тяжелые осложнения – коллапс и шок.